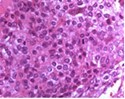

Sophomoric and Skeletal-Chondroblastoma
Abstract
A case commentary discusses a skeletal chondroblastoma with atypical features. It highlights imaging, pathology, and management considerations.
Author Contributions
Academic Editor: Qiang Cheng, Biomedical Informatics Institute, and Computer Science Department
Checked for plagiarism: Yes
Review by: Single-blind
Copyright © 2023 Anubha Bajaj.
This is an open-access article distributed under the terms of the Creative Commons Attribution License, which permits unrestricted use, distribution, and reproduction in any medium, provided the original author and source are credited.
Competing interests
The authors have declared that no competing interests exist.
Citation:
Introduction
Chondroblastoma is an exceptional, primary bone neoplasm commonly incriminating long bones. Preponderantly, tumefaction arises within a singular bone.
Majority (75%) of chondroblastomas occur within long bones wherein tumefaction arises within locations such as epiphyseal region of proximal or distal femur, proximal humerus or proximal tibia. Metaphyseal region is exceptionally involved. Tumour may incriminate calvarium of elderly subjects. Additionally, sites such as pelvis, patella, skull, ribs, scapula and navicular or carpal bones may delineate the neoplasm.
Tumefaction is encountered within 10 years to 25 years or second decade to third decade. A mild male predominance is observed with male to female proportion of 2:11, 2.
Chondroblastoma is posited to arise from cartilaginous germ cells or epiphyseal cartilage cells. Probably, multipotent mesenchymal cells or synovial cells of tendon sheath may engender the neoplasm 1, 2.
Chondroblastoma depicts K36M genomic mutation commonly delineated within H3F3B gene and exceptionally within H3F3A gene 1, 2.
Chondroblastoma is associated with pain within implicated tumour zone. Joint effusion may ensue in neoplasms occurring within articular cartilage or synovium 1, 2.
Cytological assessment demonstrates aggregates of uniform, spherical to elliptical cells intermingled with multinucleated giant cells, encompassed within a dis-cohesive matrix 1, 2.
Grossly, chondroblastoma is adherent to abutting bone and may be resected along with the bony segment. Usually, tumefaction is firm, well circumscribed, white to blue or grey and varies from 3 centimetres to 6 centimetres in magnitude 1, 2.
Cut surface exhibits variable foci of calcification, necrosis or cystic areas. Upon curettage, reddish, friable neoplastic tissue is obtained.
Upon microscopy, tumefaction is significantly cellular and composed of sheets of spherical to polyhedral chondroblastic cells imbued with abundant, eosinophilic cytoplasm and well demarcated cellular perimeter. Intracytoplasmic glycogen granules are evident. Nuclei appear elliptical, hyper-lobulated and demonstrate nuclear grooves. Nuclear atypia appears insignificant 1, 2.
Focal aggregates of spindle-shaped cells may be enunciated. Peri-cellular zones of ‘lace-like’ or ‘chicken wire’ calcification appear intermingled with degenerative chondroblasts. Eosinophilic foci of chondroid matrix are invariably discerned 1, 2.
Focal mitotic activity, necrosis and osteoclast-like giant cells may be commingled with cellular zones. Besides, aneurysmal bone cyst-like modifications are commonly observed 1, 2.
Upon ultrastructural examination, neoplastic cells simulate epiphyseal cartilage cells obtained with tissue culture and demonstrate prominent fibrous lamina with well defined cellular perimeter 1, 2.
Figure 1.Chondroblastoma demonstrating round to oval chondroblastic cells with abundant, eosinophilic cytoplasm and vesicular grooved nuclei encompassed within a myxochondroid matrix5.
Figure 2.Chondroblastoma delineating aggregates of polyhedral chondroblastic cells with angulated, abundant, eosinophilic cytoplasm and vesicular nuclei enmeshed within a chondomyxomatous matrix6.
Musculoskeletal tumour society staging (MSTS) or Enneking staging system designates benign bone and cartilaginous neoplasms as
Latent lesion composed of neoplasms such as non ossifying fibroma, enchondroma
Active lesion comprised of tumefaction as aneurysmal bone cyst, unicameral bone cyst,
chondroblastoma, chondromyxoid fibroma
Aggressive lesions constituted of neoplastic proliferations as giant cell tumour of bone2, 3.
Chondroblastoma is immune reactive to H3.3B (H3F3B), p.Lys36Met or K36M, S100 protein, DOG1 or SOX93, 4. Chondroblastoma is immune non reactive to desmin and CD34.
Chondroblastoma requires segregation form neoplasms such as chondromyxoid fibroma, giant cell tumour of bone, aneurysmal bone cyst, chondroblastoma-like sarcoma, geode or intraosseous ganglion, clear cell chondrosarcoma or osteomyelitis3, 4. Also, distinction may be necessitated from osteosarcoma, osteoblastoma, Brown’s tumour or osteoid osteoma 3, 4.
Plain radiography with anterior posterior, lateral and oblique views, computerized tomography (CT) or magnetic resonance imaging (MRI) may be adopted to appropriately discern chondroblastoma. Open surgical tissue sampling or surgical curettage can be beneficially employed for appropriate tumour discernment.
Fine needle aspiration (FNA) cytology is not recommended and is uncommon employed 3, 4.
Plain radiographs depict a well demarcated, radiolucent lesion circumscribed with an attenuated, sclerotic perimeter. Matrix calcification may or may not be observed3, 4. Tumefaction is commonly exemplified as an eccentric, radiolucent lesion within epiphysis of long bones. However, tumour extension into metaphysis may ensue.
Computerized tomography (CT) exhibits matrix calcification and solid periosteal reaction3, 4.
Magnetic resonance imaging (MRI) is optimal for delineating bone marrow oedema along with periosteal and soft tissue reaction. T2 weighted imaging exhibits variable signal intensity.
Surgical extermination or neoplastic curettage along with or in the absence of bone grafting is an optimal and recommended treatment strategy3, 4.
Chondroblastoma is appropriately alleviated with surgical curettage. En bloc surgical resection or amputation of implicated limb is beneficial in treating advanced neoplasms3, 4.
Chondroblastoma can manifest as a locally aggressive tumefaction. Tumour reoccurrence may variably ensue, contingent to site of tumour emergence3, 4.
References
- 2.Wang J, Du Z. (2022) Analysis for clinical feature and outcome of chondroblastoma after surgical treatment: A single centre experience of 92 cases. J Orthop Sci. 27(1), 235-241.
- 3.Katagiri H, Takahashi M. (2022) Direct femoral head approach without surgical dislocation for femoral head chondroblastoma: a report of two cases. BMC Surg. 22-1.
